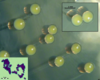

Which of the following is the glenoid labrum?
A
B
C
D
E

Which of the following is the glenoid labrum?
A
B
C
D
E
Which of the following is the acromion?
A
B
C
D
E

Which of the following is the acromion?
A
B
C
D
E
Which of the following is the scapula?
A
B
C
D
E

Which of the following is the scapula?
A
B
C
D
E
Which of the following is the supraspinatus muscle?
A
B
C
D
E

Which of the following is the supraspinatus muscle?
A
B
C
D
E

Which of the following is the glenoid labrum
A
B
C
D
E

Which of the following is the glenoid labrum
A
B
C
D
E
Which of the following is the glenoid cavity
A
B
C
D
E

Which of the following is the glenoid cavity
A
B
C
D
E
What is muscle D? [1]
What is bone E? [1]

D: supraspinatus
E: Acromion
Which of the following is the articular capsule
A
B
C
D
E

Which of the following is the articular capsule
A
B
C
D
E
Which of the following is the articular capsule
A
B
C
D
E

Which of the following is the articular capsule
A
B
C
D
E
Osteophytes are a hallmark of
Osteomalacia
Osteopenia
Osteosarcoma
Osteoarthiritis
Osteoporosis
Osteophytes are a hallmark of
Osteomalacia
Osteopenia
Osteosarcoma
Osteoarthiritis
Osteoporosis
This CT is suggestive of a patient with
Osteomalacia
Osteopenia
Osteosarcoma
Osteoarthiritis
Osteoporosis

Osteoporosis - kyphosis present

Giant osteoclasts are associated with long term treatment of which drug class? [1]

Bisphosphonates
Tinnitus may occur with which of the following bone disorders?
A. Rheumatoid arthritis
B. Paget disease
C. Multiple myeloma
D. Gout
Tinnitus may occur with which of the following bone disorders?
A. Rheumatoid arthritis
B. Paget disease
C. Multiple myeloma
D. Gout
RA
Which molecule induces sclerostin within the pathophysiological process? [1]
DKK

Which cell type breaks down hyaluronic acid in RA pathophysiology? [1]
Neutrophils
Which of the following is associated with RA?
- Heberden’s nodes
- Boutonniere deformity
- Bouchard’s nodes
- Sadness
Boutonniere deformity

Name this RA symptom [1]

Boutonniere deformity
Label A-D of RA symptoms

A: ulnar deviation
B: z-deformity
C: swan neck
D: Boutonniere deformity
RA
Label A & B

A: swan neck deformity
B: Boutonniere deformity
Seropostive (ACPA positive) RA is more likely in people with which HLA
- HLA DRB1 alleles
- HLA DRB2 alleles
- HLA DRB3 alleles
- HLA DRB4 alleles
HLA DRB1 alleles
Which of these joints would you least likely see swollen & painful joints in RA?
metacarpophalangeal (MCP)
Metatarsophalangeal (MTP)
proximal interphalangeal (PIP)
distal interphalangeal (DIP)
distal interphalangeal (DIP)
RA
NETosis is a key pathophysiological process of RA.
Which ion needs to be present for it to occur? [1]
Ca2+
State a key enzyme found in NETosis net:
PAD1
PAD2
PAD3
PAD4
PAD5
PAD4